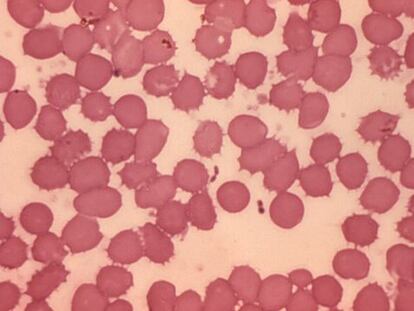

El 80% de los menores gais en Madrid no se atreve a salir del armario
Más del 40% de los alumnos cree que los profesores no ayudan ante casos de homofobia La asociación Cogam ha presentado un estudio llevado a cabo en 37 centros públicos

Más del 40% de los alumnos cree que los profesores no ayudan ante casos de homofobia La asociación Cogam ha presentado un estudio llevado a cabo en 37 centros públicos

En los países ricos aumenta el número de mujeres enfermas por tener hijos más tarde

Los famosos danzarines están de moda Antena 3 imita a TVE con el nuevo programa ‘¡A bailar!’ y Telecinco prepara un formato parecido

Besora es la empresa transportista cuyo recurso llegó al tribunal europeo, de otras 85 Pidió la devolución de 45.000 euros en impuestos en 2009
El consejero de Sanidad ha afirmado que las empresas renuncian a pedir daños y perjuicios Ribera Salud calculó en más de un millón de euros los gastos que le suponía la paralización

El Gobierno municipal vota contra la iniciativa de los ciudadanos que pedía un referéndum Centenares de vecinos se manifiestan en la plaza contra la privatización del suministro de agua

Los agentes sociales calculaban 300.000 puestos más, y solo se crearon 70.000 por los recortes y la desigualdad de aplicación entre comunidades Reclaman que la Administración fomente el empleo de cuidadores profesionales

El Gobierno municipal pretende vender el 52% de las acciones públicas para subsanar la deuda Una plataforma vecinal reclama con 11.000 firmas que la alcaldía realice una consulta popular

El colectivo de Barcelona planea sumarse al modelo impulsado en Ibiza Ejercen por voluntad propia, son autoempleadas y cotizan a la Seguridad Social

Organizaciones de mujeres aprovechan San Valentín para protestar contra la violencia de género

Metadata+ salió a la venta tras estar año y medio vetada por Apple por su contenido "¿Queremos en EE UU estar igual de conectados a nuestra política exterior que a nuestros teléfonos inteligentes?", se plantea su desarrollador, el periodista estadounidense Josh Begley

Splyce, Andara, Samplr, Camare.ro y Social Diabetes compiten por el premio

La aplicación de Marta Rueda alivia temores a través del juego

El Registro Mercantil de Madrid admite a trámite las peticiones de mujeres madrileñas que quieren protestar contra el aborto

Varios miles de personas vuelven a manifestarse en Madrid convocadas por el movimiento feminista

Save the Children inaugura una campaña de concienciación: "Y a mí quién me rescata" La ONG achaca a los recortes el aumento de menores en esta situación
Un equipo de científicos secuencia el ADN de la bacteria que causó la pandemia en época del emperador Justiniano

Grupos de activistas participan en un acto ante la Embajada en protesta por la ley de Gallardón

De la actriz Maribel Verdú a la científica Belén Valenzuela, creen que la ley será "un grave retroceso de la libertad de las mujeres españolas"

El actor Martiño Rivas protagoniza una adaptación en dos episodios del clásico 'Romeo y Julieta'

De las participantes, 12 pertenecen al IBEX 35 El programa de Igualdad no ofrece incentivos fiscales ni penalizará a las que incumplan

Los fallecidos pertenecían a la población de riesgo: con patologías respiratorias o ancianos

La Fundación BBVA premia al padre de la Inteligencia Artificial Marvin Minsky El científico ha sido elegido en la categoría de Tecnologías de Información y Comunicación Es la sexta edición del premio Fronteras del Conocimiento

La tasa de donantes queda justo debajo del máximo de 2011, con 35,12 por millón de habitantes

El país asiático lleva tres años sin registrar un solo caso La OMS certificará en marzo que el Gobierno indio ha conseguido erradicar la enfermedad

Un equipo de científicos perfora 5.023 metros en fondo marino japonés para estudiar terremotos Una de las participantes denuncia que España no paga su cuota en la organización desde 2011
El número de mujeres en altos cargos es casi la mitad de lo que dictamina la ley El sindicato de funcionarios recalca la falta de apoyo para las víctimas de violencia de género

El ruso 'Akadémik Shokálskiy' y el chino 'Xue Long' se han liberado gracias a una grieta La tripulación rusa de 22 personas y los 101 pasajeros del barco de rescate navegan hacia el norte

La cifra de perceptores de la Renta de Garantía crece en un año en cerca de 2.000 personas Los requisitos del padrón complican obtener ayudas sociales

"Lo más duro del cargo es afrontar el asesinato de una mujer", dice la directora de Emakunde

Javier Fernández-Sebastián es catedrático de Historia del Pensamiento Político en la UPV Dirige el XVI Congreso Internacional de la Historia de los Conceptos, inaugurado en Bilbao

Más de 160 académicos de 35 países acudirán este jueves y el viernes a conferencias en Bilbao

La participación sube pero la recaudación en 'txosnas' disminuye un 20% este año Bilboko Konpartsak achaca el descenso a la crisis y la "floja" oferta de conciertos
Las imágenes del desastre que en 1983 asoló Bilbao y otros municipios de la cuenca del Nervión, dejando 34 muertos

La lluvia enfría las últimas tres noches de Aste Nagusia La pregonera protagonizó un final de fiestas sin la ex 'txupinera’ Jone Artola

Algunos vecinos se resisten, mientras que los hosteleros están satisfechos

El 'lehendakari' presenta un documental que se estrenará el próximo 26 de agosto, el aniversario de las inundaciones
Son 12 los gigantes y 8 los cabezudos con los que cuenta el Ayuntamiento de Bilbao, mantenidos por la compañía de danza Bizkaiko Dantzarien Biltzarra.

El desfile cruza el Casco Viejo todas las mañanas esta Aste Nagusia. Las figuras están expuestas en el Museo Vasco

La ballena Baly abre el desfile que abarrota de niños la Gran Vía, con el espectáculo del rey Neptuno y los animales africanos como acompañantes